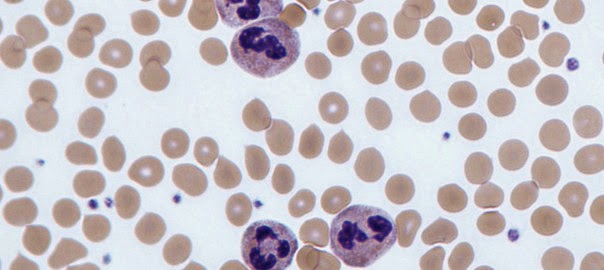

LEUCEMIA LINFOIDE AGUDA
Es un tumor que se origina en la médula ósea y que se caracteriza porque las células linfoides tumorales son inmaduras (Fidalgo, Rejas, Gopegui & Ramos, 2003).
Existen tres tipos.
L1: La más frecuente en niños, linfoblasto pequeño, citoplasma escaso, azul y nucleolos indistinguibles (Rodak, 2007).
Figura 92. Infiltración linfoblástica L1. Muestra: Médula ósea (MO)
Tinción: Wright. Aumento: 100x
Fuente: (Moneva, s.f)
L2: La más frecuente en adultos y de mal pronóstico, blasto más grande, nucleolos grandes e irregularidades de la membrana nuclear (Rodak, 2007).
Figura 93. Infiltración linfoblástica L2. Muestra: MO
Tinción: Wright. Aumento: 100x
Fuente: (Moneva, s.f)
L3: La menos frecuente y de peor pronóstico. Blasto muy grande, 3-5 nucleolos, citoplasma azul oscuro y vacuolas citoplásmicas (Rodak, 2007).
Figura 94. Infiltración linfoblástica L3. Muestra: MO
Tinción: Wright. Aumento: 100x
Fuente: (Moneva, s.f)
Manifestación clínica:
- Como en las anteriores, el cuadro clínico es consecuenca de la falta de producción de células hemáticas normales, al ser sustituida la población medular por células leucémicas:
- Anemia: Resultado de un defecto en la producción eritrocitaria, disminución de la vida media de los eritrocitos o de una pérdida franca de estas células (Rodak, 2007).
- Trombopenia: Disminución de plaquetas o de su capacidad de respuesta (Rodak, 2007).
- Las LLA (leucemia linfoide aguda), a diferencia de las LMA (leucemias mieloides crónicas), nunca están precedidas por mielodisplasias previas.
- En los niños hay que tener en cuenta los "dolores óseos", que pueden ser el síntoma de presentación de la enfermedad, y realizar un examen testicular (afectado en el 1% de los pacientes. El SNC se afecta entre el 3 y 5%.
(Moneva, s.f)
Referencias bibliográficas:
Fidalgo, L., Rejas, J., Gopegui, R. & Ramos, J. (2003). Patología médica veterinaria: Libro de texto para la docencia de la asignatura. Recuperado de: http://books.google.com.gt/books?id=GCkvIaAT1WYC&pg=PA181&dq=leucemia+linfoide+aguda&hl=es&sa=X&ei=l9NcVLrUFMiWNvOugJgE&ved=0CCUQuwUwAg#v=onepage&q=leucemia%20linfoide%20aguda&f=false
Moneva, J. (s.f). EN Boletín oncológico. Recuperado de: http://www.boloncol.com/boletin-11/leucemias.html
Rodak, F. (2007). Hematología: Fundamentos y aplicaciones clínicas. (2da. E). Recuperado de: http://books.google.com.gt/booksid=rFqhpbKnWX8C&pg=PA213&dq=anemia+ferropenica&hl=es&sa=X&ei=4tdcVLvFIIacgwTC64HgCw&sqi=2&ved=0CE8QuwUwCQ#v=onepage&q=anemia%20ferropenica&f=false